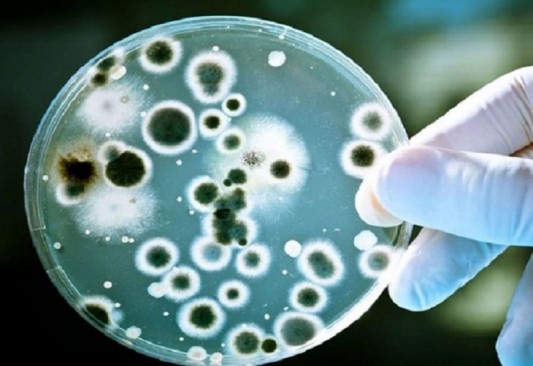

El hongo negro no es exclusivo de pacientes COVID (video)
El jefe de la Jurisdicción Sanitaria Uno, Iván Alejandro Moscoso González, explicó que el hongo negro no es una infección nueva, sino que lleva tiempo circulando entre la población que tiene comprometido su sistema inmunológico.
El hongo negro no es un nuevo fenómeno, es una infección micotica ocasionada por un hongo y es científicamente conocida como mucormicosis, ha circulado en la población desde hace tiempo, es una de las infecciones oportunistas que se establecen en pacientes infectados con el Virus de Inmunodeficiencia Humana (VIH).
Explicó que la mucomicosis es una enfermedad ocasionada por algunos tipos de hongos de algunas especies que se establecen en las personas que pudieran tener alguna deficiencia inmunológica.
Como es oportunista, aprovecha estas brechas para establecerse en las áreas de la mucosa oral o nasal e invadir al cuerpo humano, los pacientes que cursan con Covid-19. que tienen tiempo de estar internados y están expuestos a medicamentos que disminuyen su sistema inmunológico, pero no es exclusivo de ellos, recalcó.
El jefe de la Jurisdicción Sanitaria Uno recomendó acudir a las instancias medicas en un momento dado de que se cuente con una enfermedad en las vías respiratorias para asesorarse de qué medicamentos pueden tomar.
Recordarles que en algún momento de la infección se permeó la información de que había que tomar esteroides a grandes dosis y se automedicaban los pacientes, esto puede ser un factor que promueva a la infección.
Dijo desconocer si establecer al hongo negro como una enfermedad nueva es un acto intencional por parte de los médicos o de los medios de comunicación, o solo es una información emanada de la propia desinformación.
Es un tema médico y quizá la población desconozca el antecedente de la enfermedad, de alguna u otra manera, lo importante es que nosotros debemos difundir la información correcta, que es una infección micótica ocasionada por varias cepas de hongos que han circulado en nuestro territorio por mucho tiempo y se da en pacientes no solamente con Covid sino que tengan una enfermedad que compromete su sistema inmune. finalizó.